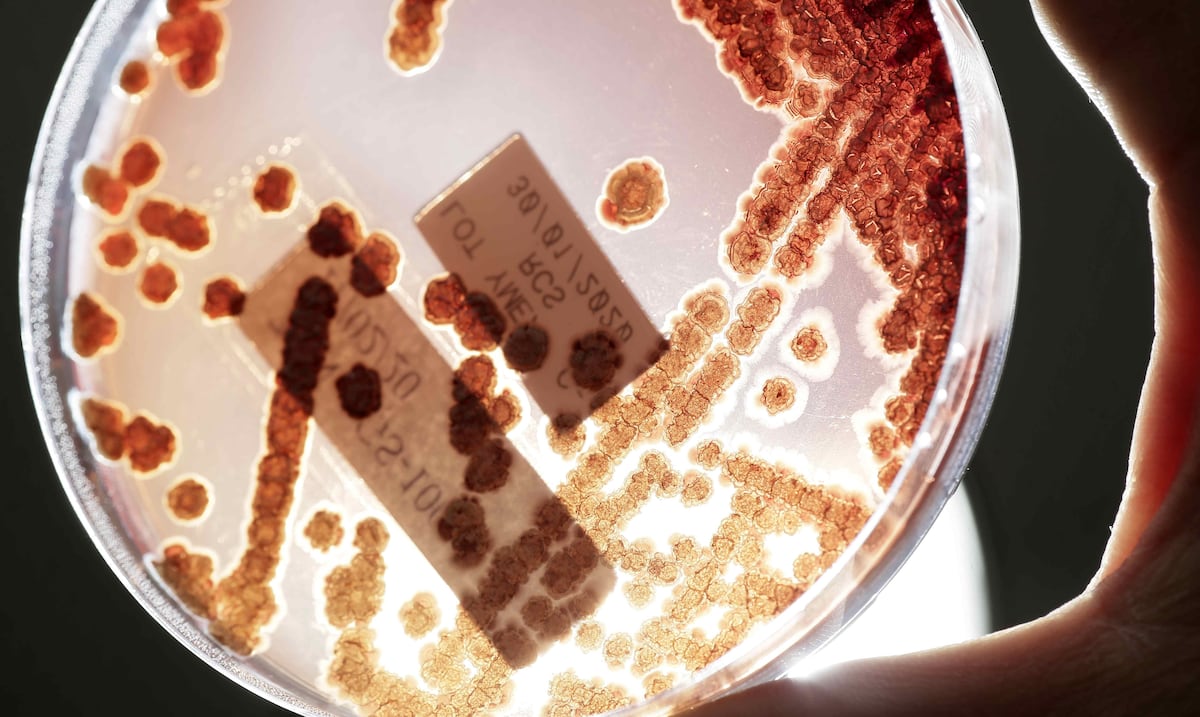
Hallan los responsables genéticos de la resistencia a los antibióticos en bacterias

¿De qué trata la nueva tedencia nutricional “loaded water” y cómo preparar esta bebida rica en potasio?
Una moda crece en Estados Unidos: la “loaded water”, un tipo de agua infusionada que mezcla esta bebida con frutas, hierbas o agua de coco para aportar sabor y minerales.Fiorella DiCarlo, dietista registrada en el